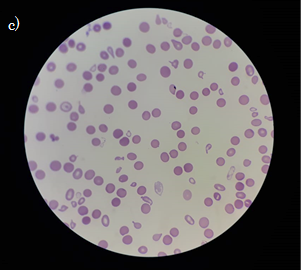
Extendido de sangre donde se observa la morfología de los eritrocitos en β-alasemia

Artículos de Revisión de Tema
Beta-Talasemia: Un mundo de complicaciones con nuevas alternativas de tratamiento
Beta-Thalassemia: A world of complications with new alternatives of treatment
Beta-Talasemia: Un mundo de complicaciones con nuevas alternativas de tratamiento
Archivos de Medicina (Col), vol. 19, núm. 1, pp. 148-159, 2019
Universidad de Manizales
Recepción: 24 Septiembre 2018
Corregido: 13 Octubre 2018
Aprobación: 10 Marzo 2019
Resumen: Introducción: β-talasemia, es causada por mutaciones en el gen de la globina HBB, que codifica la subunidad β de la HbA. La enfermedad es conocida por ser altamente prevalente en el área que se extiende desde África subsahariana, a través de la región mediterránea y Medio Oriente. En Colombia, se han reportado varios estudios independientes de hemoglobinopatías en ciudades como Cartagena, Buenaventura, Cali, San Andrés y Providencia debido a su gran población afrodescendiente sobre la cual las Talasemias y otras hemoglobinopatías tienen incidencia directa. Objetivo: recolectar datos acerca de las características clínicas, complicaciones y clasificaciones de β-talasemia con el fin de brindar una fuente de información que permita realizar un diagnóstico eficaz y en consecuencia un tratamiento que busque llegar a la curación completa de los pacientes que sufren esta condición, con el mínimo de complicaciones para los mismos. Conclusión: la β-Talasemia es una hemoglobinopatía estructural que tiene un porcentaje de prevalencia e incidencia importante en el mundo. En Colombia no se tiene claro cuál es la epidemiología real para esta condición puesto que no se han realizado estudios que abarquen una muestra adecuada y significativa. Esta enfermedad genera múltiples complicaciones en diferentes órganos, que no solo están asociadas al desarrollo de la enfermedad, sino también a la terapia de trasfusión a largo plazo. Por esta razón, los nuevos tratamientos están encaminas a lograr en un futuro la curación completa, reduciendo al máximo las complicaciones.
Palabras clave: talasemia beta, anemia de Cooley, talasemia Mayor, talasemia Menor, hemoglobinopatías, trasplante de células madre hematopoyéticas.
Abstract: Introduction: β-thalassemia is caused by mutations in the HBB globin gene, which encodes the β subunit of HbA. The disease is known to be highly prevalent in the area that stretches from sub-Saharan Africa, through the Mediterranean region and the Middle East. In Colombia, several independent studies of hemoglobinopathies have been reported in cities such as Cartagena, Buenaventura, Cali, San Andrés and Providencia due to their large Afro-descendant population on wich the thalassemias and other hemoglobinopathies.have direct incidence. Objective: to collect data about the clinical characteristics, complications and classifications of β-thalassemia in order to provide a source of information that allows an effective diagnosis and a treatment that seeks to reach the complete cure of patients that have this condition, with the minimum of complications for them. Conclusion: β-thalassemia is a structural hemoglobinopathy that has a percentage of prevalence and incidence important in the world. In Colombia it is not clear what is the real epidemiology for this condition that has not been conducted studies that include an adequate and significant sample.This disease generates multiple complications in different organs, but not only in long-term transfusion therapy. For this reason, the new treatments are aimed at achieving complete healing in the future, minimizing complications at maximum.
Keywords: beta-Thalassemia, Cooley anemia, Thalassemia major, Thalassemia minor, hemoglobinopathies, Hematopoietic stem cell transplantation.
Introducción
β-thalassemia is caused by mutations in the HBB globin gene, which encodes the β subunit of HbA. The disease is known to be highly prevalent in the area that stretches from sub-Saharan Africa, through the Mediterranean region and the Middle East. In Colombia, several independent studies of hemoglobinopathies have been reported in cities such as Cartagena, Buenaventura, Cali, San Andrés and Providencia due to their large Afro-descendant population on wich the thalassemias and other hemoglobinopathies.have direct incidence. Objective: to collect data about the clinical characteristics, complications and classifications of β-thalassemia in order to provide a source of information that allows an effective diagnosis and a treatment that seeks to reach the complete cure of patients that have this condition, with the minimum of complications for them. Conclusion: β-thalassemia is a structural hemoglobinopathy that has a percentage of prevalence and incidence important in the world. In Colombia it is not clear what is the real epidemiology for this condition that has not been conducted studies that include an adequate and significant sample.This disease generates multiple complications in different organs, but not only in long-term transfusion therapy. For this reason, the new treatments are aimed at achieving complete healing in the future, minimizing complications at maximum.
Existe un grupo de trastornos producidos por anomalías en la hemoglobina al cual se le conoce como hemoglobinopatías, que se describen como un conjunto de enfermedades hereditarias caracterizadas por síntesis, estructura y/o función anormal de la molécula de la hemoglobina [1]. Se estima que entre el 1 al 7% de la población mundial es portadora de alguno de estos desórdenes [1,2,3]; adicionalmente la Organización Mundial de la Salud estima que anualmente 330.000 recién nacidos presentan desórdenes hemoglobínicos, siendo los más graves la β-talasemia dependiente de trasfusiones y la enfermedad drepanocítica [4].
No obstante, esta revisión de tema se centrará concretamente en los aspectos concernientes a β-talasemia, la cual es causada por mutaciones en el gen de la globina HBB, que codifica la subunidad beta de la hemoglobina del adulto, la HbA. [5].
Dichas mutaciones en la subunidad Beta de la hemoglobina, resultan en fenotipos variados que van desde anemia severa hasta individuos clínicamente asintomáticos [6,7].
La tasa de natalidad en todo el mundo para la talasemia sintomática es de aproximadamente 0,44 por cada 1000 nacimientos, lo cual suma más de 40,000 recién nacidos por año que portan dicha patología [8].
La enfermedad es conocida por ser altamente prevalente en el área que se extiende desde África subsahariana, a través de la región mediterránea y Medio Oriente, al subcontinente indio y al este y Asia sudoriental [2]. En América Latina la prevalencia al nacimiento de talasemia es de 0,10/1.000 [9]. En Colombia, se han reportado varios estudios independientes de hemoglobinopatías en ciudades como Cartagena, Buenaventura, Cali, San Andrés y Providencia debido a su gran población afrodescendiente sobre la cual las Talasemias y otras hemoglobinopatías tienen incidencia directa [10,11]. No se han obtenido datos de otras partes del país donde existe una mezcla de población diferente y por lo tanto, se desconoce la incidencia real de hemoglobinopatías a nivel nacional; sin embargo, hay reportes que señalan que la prevalencia encontrada para hemoglobinopatías en Medellín es de un 3.5% [10,12].
Los niños afectados pueden presentar retraso en el crecimiento u otros signos o síntomas más específicos como distensión abdominal, hepatoesplenomegalia por hematopoyesis extramedular, irritabilidad e ictericia, los cuales requieren manejo de la enfermedad de por vida, puesto que las personas con una enfermedad grave no sobrevivirán a la infancia sin un tratamiento adecuado [6,13].
El diagnóstico es generalmente confirmado por el uso de técnicas electroforéticas o análisis moleculares [8]. La Beta-Talasemia se ha clasificado tradicionalmente como mayor, intermedia o menor según la gravedad del fenotipo clínico [8]. Sin embargo, en la última década, ha habido una transición a un sistema de clasificación más simple basado en los requisitos de transfusión de sangre. Hoy en día, se considera que los pacientes tienen talasemia dependiente de transfusión (TDT) o talasemia no dependiente de transfusiones (NTDT) [8,14].
Las hemoglobinopatías y en este caso la Beta-Talasemia, son trastornos con una incidencia considerable en la población mundial y con influencia en la mortalidad, por lo que es de vital importancia el estudio de las mismas, no solo para llegar al adecuado diagnóstico de estas, sino también con el fin de aplicar de manera correcta los tratamientos ya existentes y buscar nuevas alternativas de los mismos.
Fisiopatología
La hemoglobina es la proteína que transporta el oxígeno de los pulmones a los tejidos y está formada por un tetrámero compuesto por dos cadenas tipo α y dos cadenas tipo no α [1,15].Normalmente, a lo largo del desarrollo del individuo se da la síntesis de diversas cadenas que derivan en variantes de hemoglobina, como es el caso de la producción de α-globina que comienza durante el desarrollo fetal y es constante a lo largo de la vida [6], mientras que, la γ-Globina se activa durante el desarrollo embrionario temprano para crear HbF (α2γ2), que generalmente disminuye en los primeros 6 meses después del nacimiento [6]. Por otro lado, se da también la producción de β-globina, esta comienza a finales de la gestación para crear HbA (α2β2), que alcanza los niveles de adultos en 1 año de vida [6]. Normalmente en las personas mayores de un año de edad, cerca del 95% de la hemoglobina corresponde a hemoglobina A (α2β2), el 3,5% a hemoglobina A2 (a2 δ2 ) y menos de 1% a hemoglobina fetal (α2γ2) [1].
Como ya se había mencionado previamente, la β-Talasemia se presenta en consecuencia a mutaciones en el gen de la globina HBB, mutación de ubicación específica en el cromosoma 11, el cual codifica la subunidad β de la HbA [5]. En virtud de estas mutaciones, se pueden presentar dos escenarios: la supresión completa (mutaciones β0) o la disminución (mutaciones β+ y β++) en la producción de cadenas β globina, lo que deriva en un desequilibrio en la síntesis de cadenas de globina α/β [1] (Figura 1a, 1b, 1c.). La magnitud de este desequilibrio es el determinante principal del fenotipo de la enfermedad, la cual oscila entre pacientes asintomáticos (β-talasemia NTDT o portador), hasta los pacientes que dependen de transfusiones regulares para vivir TDT [1].

En la β-talasemia, la acumulación de tetrámeros de la cadena α-globina inestable en células eritroides conduce a la muerte celular prematura dentro (eritropoyesis ineficaz) y fuera (hemólisis periférica) de la médula ósea, esto es facilitado por la formación de especies de oxígeno reactivas y deformidades estructurales de la membrana llevando a la exposición del antígeno de senescencia; circunstancia que se manifiesta clínicamente como una anemia hemolítica crónica [2].
Esta apoptosis incrementada de eritrocitos se asocia con un aumento de la expresión de la fosfatidilserina, una importante señal para la remoción prematura por macrófagos medulares hiperplásicos de eritroblastos con rigidez de su citoesqueleto [16].
En las formas TDT de β-talasemia los cuadros fisiopatológicos de hemólisis y de hipercoagulabilidad se deben a la oxidación de las subunidades α, β, o γ de la Hb, lo cual lleva a la constitución de hemicromos cuyo grado determina respectivamente, la hemólisis [16]. Estos hemicromos se unen o modifican varios componentes de la membrana eritrocitaria, en los cuales, luego de su precipitación como cuerpos de inclusión ocurre una desintegración del grupo hem y en consecuencia la liberación de hierro que cataliza la formación de especies de oxígeno reactivo [16], que como resultado, lleva a la generación aumentada y exteriorizada de fosfatidilserina, que provoca una activación del sistema de la coagulación y de las plaquetas [16].
Clasificaciones de la β-talasemia:
Talasemias dependientes de transfusiones.(TDT)
Resulta a causa de un estado homocigotico en el paciente para el gen de dicha enfermedad [17]. Generalmente, los signos y síntomas aparecen en los primeros dos años de vida, periodo en el cual dichos individuos desarrollan una anemia que amenaza con su vida (hemoglobina (Hb) <7.0 g/dl) [18]. Es uno de los trastornos hereditarios más comunes que genera altos gastos en el sistema de salud en todo el mundo [19]. Debido a la severidad de su presentación, es una enfermedad compleja que requiere una terapia médica especial, en la que se administran transfusiones de sangre regulares acompañados de terapia de quelación, que resultan necesarias para la supervivencia de estos individuos [20]. Dichos pacientes dependientes de transfusiones con β-talasemia, derivan en un amplio espectro de complicaciones que surgen de las transfusiones obligatorias de por vida de glóbulos rojos concentrados, sobre los cuales se hablará más adelante [21].
Existen casos en los que ciertos individuos homocigotos presentan con menos severidad las manifestaciones de esta enfermedad [17]. En dicha circunstancia, los signos y síntomas propios de la misma como: anemia (leve a moderada (Hb 7.0 a 9.0 g/dl)), ictericia, esplenomegalia, hiperesplenismo, anomalías óseas, eritropoyesis extramedular, sobrecarga de hierro, úlceras en piernas y cálculos biliares aparecen después de los primeros dos años de vida [18,22,23].
El manejo de los pacientes con TDT es particularmente desafiante para los médicos, ya que no solo pueden presentar una gran cantidad de complicaciones, que varían en severidad, sino que además hasta hace poco había pocas pautas claras sobre el tratamiento de la enfermedad, lo cual puede generar barreras en el mismo [24].
β- talasemia no dependiente de transfusiones (NTDT).
Se refiere a aquellos individuos portadores heterocigotos del gen de esta afección [17]. Clínicamente tiene un curso más leve que aquellos con β-talasemia TDT, presentándose con una anemia más o menos marcada que no requiere tratamiento con transfusiones de sangre regulares [25]. Estos pacientes son usualmente asintomáticos [25]. A menudo tienen anemia leve que varía entre 9 y 11 g/dl; que se caracteriza por ser microcítica hipocrómica y en ocasiones, incluso pueden tener niveles normales de hemoglobina [26]. Esta anemia, empeora en presencia de deficiencia nutricional, como en los casos de deficiencia de hierro, ácido fólico o vitamina B12 [26]. En cuanto a los recuentos de glóbulos rojos, estos pueden ser normales o aumentar ligeramente [26].
Tratamiento
Como ya se ha mencionado en la β-talasemia, la síntesis ausente o reducida de la cadena de β-globina conduce a eritropoyesis ineficaz y hemólisis periférica, la cual se manifiesta clínicamente en su variante más grave como una anemia dependiente de transfusiones de glóbulos rojos asociada a terapia de quelación [27]. Sin embargo, el alotrasplante de células madre hematopoyéticas (TCMH) sigue siendo la única opción de tratamiento curativo desde el primer trasplante de médula ósea (TMO) para β las TDT reportado en diciembre de 1981 [28,29].
El TCMH es una estrategia efectiva para curar la β-talasemia severa en niños con una tasa de éxito demostrada de hasta 90% [30]. Las células madre compatibles con el antígeno leucocitario humano (HLA) de un hermano idéntico no afectado se consideran la mejor estrategia para los pacientes con β-talasemia que requieren un trasplante alogénico [31]. Sin embargo, solo una pequeña proporción de pacientes tiene donantes compatibles en HLA y se suma a este hecho, las toxicidades de procedimiento que se acompañan con una tasa de mortalidad de 5-10%, que limitan este enfoque a únicamente una fracción de los individuos afectados [32,33].
Existen ciertas condiciones que se presentan al realizar esta terapia curativa, tales como la enfermedad de injerto contra huésped y las reacciones inmunes adversas, las cuales pueden limitar el éxito del trasplante [32].
El riesgo de rechazo de este trasplante en β-talasemia es mayor que en los realizados para trastornos malignos [34]. Respecto al riesgo de rechazo, al igual que en los pacientes transfundidos con anemia aplásica, el mayor riesgo de rechazo en la β-talasemia se ha atribuido a la excesiva exposición previa a los trasplantes de sangre, lo que lleva a la aloinmunización [34].
En los últimos años, gracias a los avances en el conocimiento de la fisiopatología del hierro, se ha implicado a las especies de hierro reactivas que se encuentran en los tejidos con la toxicidad orgánica, lo cual es apoyada también por factores ambientales como infecciones [35]. Esto sustenta la importancia de la terapia de quelación continua de hierro tóxico antes y después del TCMH para obtener mejores resultados [35].
Recientemente, se ha propuesto el uso de trasplante de células madre de sangre periférica de un donante hermano con el HLA compatible en lugar de médula ósea (MO) con el objetivo de prevenir la falla en la tolerancia del injerto en TDT [36].
Dadas las limitaciones en este tratamiento de trasplante, la terapia génica mediante una modificación ex vivo de células madre hematopoyéticas (CMH) seguida de un injerto autólogo, es una nueva modalidad terapéutica atractiva [37]. Esta nueva alternativa es especialmente novedosa, sobretodo para pacientes que no tienen un donante compatible emparejado, en los cuales la terapia génica con globina ofrece la promesa de un trasplante de células madre autólogo curativo sin incurrir en los riesgos de la enfermedad de injerto contra huésped [38].
El objetivo de la transferencia génica de globina es restaurar la capacidad de las células madre hematopoyéticas del paciente con talasemia para generar glóbulos rojos con un contenido de hemoglobina normal [38]. Solo las CMH transducidas pueden proporcionar beneficios clínicos a largo plazo a través de una eritropoyesis productiva basada en un proceso normalizado en la relación de síntesis de la cadena α/β globina [39]. Por lo tanto, con la ayuda de la terapia celular y génica para la talasemia, se busca lograr la independencia de las transfusiones continuas de sangre, evitándose exponer a los pacientes a los riesgos del TCMH a partir de un donante con compatibilidad subóptima [39].
Gracias a los estudios realizados sobre este nuevo tratamiento, es posible que pueda extenderse a la mayoría de los pacientes con TDT, ya que con este procedimiento no hay preocupación por las complicaciones relacionadas con histocompatibilidad y el régimen de acondicionamiento no necesita incluir fármacos inmunosupresores [40].
El resultado de la terapia genética depende de diferentes variables, incluida la fuente del TCMH, la eficacia de la transducción (como porcentaje de células transducidas), el número promedio de copias del vector logradas durante la transducción in vitro, la persistencia in vivo, la intensidad de la mieloablación, la dosis y el injerto de CMH genéticamente modificadas infundidas y finalmente, el estado de microambiente de la MO [41].
La β-talasemia es uno de los primeros ejemplos en que la terapia génica podría aplicarse a una gran población de pacientes que residen principalmente en países en desarrollo [42]. Por lo tanto, a gran escala, la viabilidad y la gestión de costos de este tratamiento potencialmente curativo, así como de otras terapias genéticas desarrolladas para la β-talasemia, presenta enormes desafíos para la comunidad de terapia génica [41].
Complicaciones de la β-Talasemia
La aparición de métodos no invasivos para medir el hierro orgánico antes de la aparición de los síntomas clínicos junto con los nuevos quelantes de hierro han reducido la incidencia de complicaciones relacionadas con la sobrecarga de hierro [43]. Sin embargo, a pesar de la correcta aplicación de intervenciones diagnósticas y terapéuticas los pacientes talasémicos pueden experimentar enfermedades secundarias o complicaciones que han asumido un papel nuevo e importante en el curso de esta enfermedad en los últimos años [43,44]. La hipoxia, la eritropoyesis ineficaz y la sobrecarga de hierro contribuyen a producir las complicaciones en múltiples órganos; de los cuales el hígado, el corazón y las glándulas endocrinas son los órganos afectados con mayor frecuencia y es en quienes finalmente se observan complicaciones cirrosis, insuficiencia cardíaca y defectos endocrinos (hipotiroidismo, hipopituitarismo, hipogonadismo, hipoparatiroidismo) [45]. A continuación se hablará de algunas de estas de manera más detallada.
Sobrecarga de hierro
- Pacientes no transfundidos regularmente
En estos pacientes se observa: eritropoyesis ineficaz, niveles inadecuados de hepcidina, aumento de la absorción intestinal de hierro, mayor liberación del hierro reciclado del sistema reticuloendotelial, agotamiento del hierro de los macrófagos, niveles relativamente más bajos de ferritina sérica y liberación a la circulación de especies de hierro libres [24].
- Pacientes transfundidos regularmente
A diferencia de los pacientes que no son transfundidos regularmente, estos no tienen niveles disminuidos de hepcidina, el hierro se distribuye principalmente al sistema reticuloendotelial, estimulando la síntesis de ferritina, la cual se libera a la circulación dando como resultado el aumento de sus niveles séricos [24].
Deterioro del crecimiento
Los niños con talasemia corren el riesgo de sufrir falla de crecimiento debido a la anemia crónica, y estado hipermetabólico que es consecuencia de la eritropoyesis ineficaz de gran volumen [46]. Las deficiencias nutricionales, la toxicidad de la quelación y las endocrinopatías inducidas por hierro también contribuyen a un crecimiento lineal y aumento de peso subóptimos [46]. El desarrollo puberal también puede retrasarse [46].
Anormalidades óseas
En pacientes talasémicos, la enfermedad ósea es una causa importante de morbilidad. Varias de estas complicaciones óseas incluyen osteopenia, osteoporosis, escoliosis, raquitismo, deformidades espinales, compresión del nervio y fracturas espontáneas, las cuales se informan regularmente en talasémicos dependientes de transfusiones [47]. Existen diversos factores que contribuyen a la enfermedad ósea, incluida la expansión medular, la acumulación de hierro, el equilibrio anormal de calcio y fósforo, el alto recambio óseo, la insuficiencia hormonal y, por último, la hipoxia pueden influir en dichas complicaciones [47].
Esplenomegalia e hiperesplenismo
El agrandamiento esplénico en la talasemia puede ser causado por hematopoyesis extramedular y secuestro de glóbulos rojos defectuosos [46]. La esplenomegalia es particularmente problemática en pacientes que no reciben una transfusión adecuada y puede causar leucopenia, trombocitopenia y exacerbación de la anemia por hiperesplenismo [46]. La esplenectomía sola puede ser suficiente para controlar la anemia, puede estar indicada en pacientes con TDT cuyos requisitos de transfusión son más altos de lo esperado [46].
Endocrinopatías
Aunque la supervivencia de los pacientes con β-Talasemia ha mejorado, las complicaciones endocrinas continúan comprometiendo el crecimiento y la calidad de vida [48]. Estas son causadas por daño del eje hipotalámico o daño directo del órgano final manifestándose como una falla de crecimiento, hipotiroidismo, hipoparatiroidismo, diabetes mellitus e hipogonadismo [49]. La prevalencia de endocrinopatías en β-Talasemia está directamente relacionada con el nivel de sobrecarga de hierro [50]. A pesar de la pubertad retrasada, estos pacientes todavía tienen un desarrollo sexual y fertilidad normales [50].
Enfermedad renal
Los niveles altos de hierro local en el riñón pueden causar daño renal que eventualmente puede progresar a enfermedad renal terminal. Esta condición puede desarrollarse a través de lesiones túbulo-intersticiales y / o glomerulares. La disfunción renal puede ocurrir en pacientes asintomáticos con TDT incluso antes de tener las manifestaciones de cualquier otra complicación [50]. Existen Varios factores principales que pueden ser responsables de la disfunción renal asociada con TDT, incluida la reducción de la vida de los glóbulos rojos, la hipoxia crónica, el rápido recambio de hierro y la deposición de exceso de hierro en los tejidos [51]. Además, el uso de quelantes de hierro específicos puede dañar el riñón [51].
Hipertensión pulmonar
La disfunción miocárdica y la insuficiencia cardíaca se consideraron como causas comunes de morbilidad y mortalidad en niños con β-TDT, que se relacionan principalmente con hemólisis crónica y sobrecarga de hierro [52]. Sin embargo, la hipertensión arterial pulmonar (HAP) se ha convertido en un factor de riesgo importante para alteración de la función ventricular derecha en tales pacientes [52]. La HAP es un trastorno vascular complejo y multifactorial, el principal mecanismo subyacente de HAP en pacientes con β-talasemia aún no se conoce; sin embargo, se sugiere que la interacción de varios factores, incluyendo activación plaquetaria, hemólisis crónica, angiogénesis disfuncional, estrés oxidativo y sobrecarga de hierro, están relacionados con la génesis de esta complicación [52].
Estado de hipercoagulabilidad
El aumento de la adhesión plaquetaria en la β-talasemia, se correlaciona con eventos trombóticos clínicos, lo cual podría deberse al contacto directo con los glóbulos rojos patológicos que expresan niveles anormalmente altos de fosfolípidos cargados negativamente, principalmente fosfatidilserina en su membrana [53]. Por otro lado, existen otros factores que contribuyen al estado de hipercoagulabilidad crónica en la talasemia dentro de los cuales se encuentran la deficiencia de inhibidores del factor de la coagulación como la proteína C y la proteína S, la disfunción cardíaca, hepática y las deficiencias hormonales debidas a la acumulación de hierro en órganos vitales [53].
El estrés oxidativo también puede llevar a un estado de hipercoagulabilidad crónico ya que puede estimular la activación y agregación de las plaquetas e inducir la externalización de la fosfatidilserina [53].
Cardiacas
En las TDT, las transfusiones de por vida causan sobrecarga de hierro y hemosiderosis en diferentes órganos, siendo la de localización cardíaca la causa más común de muerte en estos paciente [54]. Aunque la terapia de quelación con hierro ha mejorado el pronóstico y la supervivencia en la β-talasemia, los pacientes están aún sujetos al daño oxidativo, donde el corazón es particularmente susceptible, lo cual puede conducir a insuficiencia cardíaca, donde La disfunción cardíaca es tradicionalmente relacionada a la disfunción sistólica severa del ventrículo izquierdo [55,56].
Hepáticas
La enfermedad hepática es frecuente en pacientes con talasemia, debido a que, además de ser es un sitio importante de deposición de hierro, también existe alta prevalencia de infecciones virales de transmisión sanguínea con hepatotropía [57]. La sobrecarga de hierro hepático es una causa de fibrosis y cirrosis, especialmente cuando está asociada con infección por el virus de la Hepatitis C (VHC); es por esto, que en estos pacientes, la biopsia hepática sigue siendo útil para la evaluación del daño hepático en hepatitis crónica y es recomendado por directrices internacionales porque permite graduar la necroinflamación y la estadificación de la fibrosis hepática, la evaluación de la esteatosis y el diagnóstico de la cirrosis según los puntajes estandarizados. La prevalencia de la cirrosis en los pacientes con talasemia oscila entre 10 y 20% [57].La cirrosis es un factor de riesgo para el desarrollo de carcinoma hepatocelular y es una causa importante de insuficiencia hepática [57].
Conclusión
La β-Talasemia es una hemoglobinopatía estructural que tiene un porcentaje de prevalencia e incidencia importante en el mundo, el cual ha venido en aumento y se ha expandido a diferentes países como consecuencia de los flujos migratorios .En el caso específico de Colombia no se tiene claro cuál es la epidemiología real para esta condición puesto que no se han realizado estudios que abarquen una muestra adecuada y significativa de los habitantes de las diferentes zonas del país que posean esta afección. Sin embargo, en la mayor parte de estos estudios se hace énfasis en la necesidad de implementar tamizajes no solo para adquirir una cifra epidemiológica más acertada, sino también para el diagnóstico precoz de esta enfermedad.
A lo largo de los años las clasificaciones clínicas de la enfermedad han cambiado, anteriormente se clasificaba según la gravedad del fenotipo clínico en β-Talasemia mayor, intermedia y menor, sin embargo en la actualidad se ha simplificado un poco y se clasifica con respecto a la necesidad o no de trasfusiones en TDT o NTDT.
Esta enfermedad es una condición que genera múltiples complicaciones en diferentes órganos que pueden alcanzar un alto grado de severidad, que incluso puede conllevar a la muerte del individuo. Estas no solo están asociadas al desarrollo de la enfermedad, sino también a la terapia de trasfusión a largo plazo, razón por la cual, los nuevos tratamientos como el TCHM y la terapia génica mediante una modificación ex vivo de células madre hematopoyéticas están encaminas a lograr en un futuro la curación completa de la enfermedad al alcance de todos los pacientes afectados, reduciendo al máximo las complicaciones y la mortalidad relacionada a esta afección.
Conflictos de interés: los autores declaran que no existen conflictos de interés.
Fuentes de financiación: no se contó con financiación externa para la elaboración de este manuscrito.
Literatura citada
Eandi S, Pepe C, Aguirre F, Milanesio B, Fernández D, Mansini, et al. Beta talasemia intermedia: características clínicas y estudio molecular. Serie de casos clínicos. Arch Argent 2015; 113(5):e294-e298. DOI: 10.5546/aap.2015.e294.
Taher AT, Weatherall DJ, Cappellini MD. Thalas- saemia. Lancet 2018; 391(10116):155-167. DOI: 10.1016/S0140-6736(17)31822-6
McGann PT, Nero AC, Ware RE. Clinical Features of β-Thalassemia and Sickle Cell Disease. Adv Exp Med Biol 2017; 1013:1-26. DOI: 10.1007/978- 1-4939-7299-9_1.
Hladun R, Elorza I, Olivé T, Dapena JL, Llort A, Sánchez-de-Toledo J, et al. [Results of hematopoietic stem cell transplantation in hemoglobinopathies: thalassemia major and sickle cell disease]. An Pediatr (Barc) 2013; 79(2):75-82. DOI:10.1016/j. anpedi.2012.12.002.
Thompson AA, Walters MC, Kwiatkowski J, Rasko JEJ, Ribeil JA, Hongeng S, et al. Gene Therapy in Patients with Transfusion-Dependent β-Thalassemia. N Engl J Med 2018; 378(16):1479- 1493. DOI: 10.1056/NEJMoa1705342
Martin A, Thompson AA. Thalassemias. Pediatr Clin North Am 2013; 60(6):1383-91. DOI: 10.1016/j. pcl.2013.08.008.
Lazarte S, Leri M, Jiménez C, Haro A, Burgos M, Issé B. Resistencia osmótica eritrocitaria en el diagnóstico de anemias hereditarias en Tucumán, Argentina.Acta Bioquím Clín Latinoam 2012; 46(4):645-53.
Bollig C, Schell LK, Rücker G, Allert R, Motschall E, Niemeyer CM, et al. Deferasirox for managing iron overload in people with thalassaemia. Cochrane Database Syst Rev 2017; 8:CD007476. DOI:10.1002/14651858.
Rey J. Tamizaje de Hemoglobinopatías en una Muestra de la Población Infantil de Cartagena. Pediatría. 1998; 33(2):86-9
Echeverry SJ, Colmenares CC, Yepes ZX, Martínez O, Isaza MA. Hemoglobinopathy detection through an institutional neonatal screening program in Colombia. J Bras Patol Med Lab 2016; 52(5):299-306. DOI: 10.5935 16762444.20160050
Castillo M, Oliveros A. Caracterización de alteraciones en la molécula de hemoglobina en afrodescendientes colombianos. Nova 2014; 12(22):151-156. DOI: 10.22490/24629448.1039.
Restrepo F, Loaiza N, Arrubla M, Cossio SP, Ordóñez J.. Estudio de prevalencia de anemia falci- forme y otras hemoglobinopatías en población de recién nacidos del área Metropolitana de Medellín. Medellín: Laboratorio Clínico Prolab; 2010.
Cappellini MD, Porter JB, Viprakasit V, Taher AT. A paradigm shift on beta-thalassaemia treatment: How will we manage this old disease with new therapies?Blood Rev 2018; 32(4):300-311. DOI: 10.1016/j.blre.2018.02.001
Taher AT, Cappellini MD. How I manage medical complications of beta-thalassemia in adults. Blood 2018; 132(17):1781-1791. DOI:10.1182/ blood-2018-06-818187.
Cavazzana M, Antoniani C, Miccio A. Gene Therapy for β-Hemoglobinopathies. Mol Ther. 2017; 25(5):1142-1154. DOI: 10.1016/j.ymthe.2017.03.024
Sáenz-Renauld GF, Rodríguez-Romero W. Síndromes talamésicos. Nuevos conceptos y estado actual del conocimiento en Costa Rica. Acta Méd. Costarric 2006; 48(4):172-178.
Zarei T, Dehbozorgian J, Imanifard J, Setoodegan F, Karimi M. A Number of Cases in Iran Presenting with Coinheritance of Hemoglobin-H Disease and Beta-Thalassemia Minor. Hemoglobin 2016; 40(5):316-318.
Graffeo L, Vitrano A, Scondotto S, Dardanoni G, Pol- lina Addario WS, Giambona A, et al. β-Thalassemia heterozygote state detrimentally affects health expectation.Eur J Intern Med 2018; 54:76-80. DOI: 10.1016/j.ejim.2018.06.009.
Dhouib NG, Ben Khaled M, Ouederni M, Besbes H, Kouki R, Mellouli F, et al. Growth and Endocrine Function in Tunisian Thalassemia Major Patients. Mediterr J Hematol Infect Dis 2018; 10(1):e2018031. DOI: 10.4084/MJHID.2018.031.
Saeedi Kia N, Karami K, Mohamadian H, Malehi AS. Evaluation of an educational intervention based on health belief model on beta thal- assemia carrier and finalsuspects couples.J Educ Health Promot 2018; 7:77. DOI: 10.4103/ jehp.jehp_103_16.
Cunningham M, Macklin E, Neufeld E, Cohen A. Complications of -thalassemia major in North America. Blood 2004; 104(1):34-39. DOI:10.1182/ blood-2003-09-3167.
Tsartsalis AN, Lambrou GI, Tsartsalis D, Savvidis C, Karantza M, Terpos E, et al. The role of biphos- phonates in the management of thalassemia-in- duced osteoporosis: a systematic review and meta-analysis. Hormones (Athens) 2018; 17(2):153-166. DOI: 10.1007/s42000-018-0019-3.
Borgna-Pignatti C, Marsella M, Zanforlin N. The natural history of thalassemia intermedia.Annals Of The New York Academy Of Sciences 2010; 1202:214- 20. DOI: 10.1111/j.1749-6632.2010.05550.x.
Adly AA, Ismail EA. Management of Children With β-Thalassemia Intermedia: Overview, Recent Advances, and Treatment Challenges.J Pediatr Hematol Oncol 2018; 40(4):253-268. DOI: 10.1097/ MPH.0000000000001148.
Lazarte SS, Mónaco ME, Terán MM, Haro AC, Achem MEL, Issé BA. Foxo3 gene expression and oxidative status in beta-thalassemia minor subjects.Rev Bras Hematol Hemoter 2017; 39(2):115-121. DOI: 10.1016/j.bjhh.2017.01.005.
Choudhry VP. Thalassemia Minor and Major: Current Management. Indian J Pediatr 2017 84(8):607-611. DOI: 10.1007/s12098-017-2325-1.
Rahal I, Galambrun C, Bertrand Y, Garnier N, Paillard C, Frange P, et al. Late effects after hematopoietic stem cell transplantation for β-thalassemia major: the French National experience. Haematologica 2018; 103(7):1143-1149. DOI:10.3324/haematol.2017.183467.
Park BK, Kim HS, Kim S, Lee JW, Park YS, Jang PS, et al. Allogeneic hematopoietic stem cell transplantation in congenital hemoglobinop- athies with myeloablative conditioning and rabbit anti-thymocyte globulin. Blood Res 2018; 53(2):145-151. DOI: 10.5045/br.2018.53.2.145.
Li XY, Sun X, Chen J, Qin MQ, Luan Z, Zhu YP, et al. Hematopoietic stem cell transplantation for children with β-thalassemia major: multicenter experience in China. World J Pediatr 2018; 14(1):92-99. DOI: 10.1007/s12519-017-0107-5.
Zhang X, Hao W, Xu T, Liu S, Jiang H. Diagnosis and treatment of neoplastic post-transplant lymphoproliferative disorder following hemato- poietic stem cell transplant in β-thalassemia: A pediatric case report.Medicine (Baltimore) 2017; 96(52):e9055. DOI:10.1097/MD.0000000000009055
Gabr H, Youssry I, El-Ansary Y, Mosallam G, Riad NM, Hanna MOF. Chimerism in pediatric hemato- poietic stem cell transplantation and its correla- tion with the clinical outcome.Transpl Immunol 2017; 45:53-58. DOI: 10.1016/j.trim.2017.09.004.
Dong AC, Rivella S. Gene Addition Strategies for β-Thalassemia and Sickle Cell Anemia. Adv Exp Med Biol 2017; 1013:155-176. DOI: 10.1007/978- 1-4939-7299-9_6.
Fitzhugh CD, Abraham A, Hsieh MM. Alternative Donor/Unrelated Donor Transplants for the β-Thalassemia and Sickle Cell Disease. Adv Exp Med Bio 2017; 1013:123-153. DOI: 10.1007/978- 1-4939-7299-9_5.
Korula A, Pn N, Devasia A, Lakshmi KM, Abraham A, Sindhuvi E, et al. Second Hematopoietic Stem Cell Transplant for Thalassemia Major: Improved Clinical Outcomes with a Treosul- fan-Based Conditioning Regimen. Biol Blood Marrow Transplant 2018; 24(1):103-108. DOI: 10.1016/j.bbmt.2017.10.012.
Chaudhury S, Ayas M, Rosen C, Ma M, Viqaruddin M, Parikh S, et al. A Multicenter Retrospective Analysis Stressing the Importance of Long-Term Follow-Up after Hematopoietic Cell Transplan- tation for β-Thalassemia. Biol Blood Marrow Transplant 2017; 23(10):1695-1700. DOI: 10.1016/j. bbmt.2017.06.004.
Angelucci E, Matthes-Martin S, Baronciani D, Bernaudin F, Bonanomi S, Cappellini MD, et al . Hematopoietic stem cell transplantation in thalas- semia major and sickle cell disease: indications and management recommendations from an international expert panel.Haematologica 2014; 99(5):811-20. DOI: 10.3324/haematol.2013.099747.
Sii-Felice K, Giorgi M, Leboulch P, Payen E. Hemoglobin disorders: lentiviral gene therapy in the starting blocks to enter clinical practice. Exp Hematol 2018; 64:12-32. DOI: 10.1016/j.ex- phem.2018.05.004.
Boulad F, Mansilla-Soto J, Cabriolu A, Rivière I, Sadelain M. Gene Therapy and Genome Editing. Hematol Oncol Clin North Am 2018; 32(2):329-342. DOI:10.1016/j.hoc.2017.11.007.
Mansilla-Soto J, Riviere I, Boulad F, Sadelain M. Cell and Gene Therapy for the Beta-Thal- a ssemias : A dva nc es a nd Pr os pe cts . H um Gene Ther 2016; 27(4):295-304. DOI: 10.1089/ hum.2016.037.
Negre O, Eggimann AV, Beuzard Y, Ribeil JA, Bourget P, Borwornpinyo S,et al. Gene Therapy of the β-Hemoglobinopathies by Lentiviral Transfer of the β(A(T87Q))-Globin Gene. Hum Gene Ther 2016; 27(2):148-65. DOI: 10.1089/hum.2016.007.
Ferrari G, Cavazzana M, Mavilio F. Gene Therapy Approaches to Hemoglobinopathies. Hematol Oncol Clin North Am 2017; 31(5):835-852. DOI: 10.1016/j.hoc.2017.06.010.
Biffi A. Gene Therapy as a Curative Option for β-Thalassemia. N Engl J Med 2018; 378(16):1551-1552. DOI: 10.1056/NEJMe1802169.
Floris F, Comitini F, Leoni G, Moi P, Morittu M, Orecchia V, et al. Quality of life in Sardinian patients with transfusion-dependent Thalas- semia: a cross-sectional study.Qual Life Res 2018; 27: 2533–2539. DOI: 10.1007/s11136-018- 1911-7.
Bonifazi F, Conte R, Baiardi P, Bonifazi D, Felisi M, Giordano P,et al; HTA-THAL Multiregional Registry. Pattern of complications and bur- den of disease in patients affected by beta thalassemia major. Curr Med Res Opin 2017; 33(8):1525-1533. DOI:10.1080/03007995.2017.1326890.
Guidotti F, Piatti G, Marcon A, Cassinerio E, Giuditta M, Roghi A,et al. Pulmonary dysfunction in thalassaemia major: is there any relationship with body iron stores?. Br J Haematol 2017; 176(2):309-314. DOI: 10.1111/bjh.14396.
Martin A, Thompson AA. Thalassemias. Pediatr Clin North Am 2013; 60(6):1383-91. DOI: 10.1016/j.pcl.2013.08.008.
Sultan S, Irfan SM, Ahmed SI. Biochemical Markers of Bone Turnover in Patients with β-Thalassemia Major: A Single Center Study from Southern Pakistan. Adv Hematol 2016; 2016:5437609. DOI: 10.1155/2016/5437609.
Sharma R, Set h A , Chandra J , G ohain S, Kapoor S, Singh P, et al. Endocrinopathies in adolescents with thalassaemia major receiving oral iron chelation therapy. Paediatr Int Child Health 2016; 36(1):22-7. DOI: 10.1179/2046905514Y.0000000160.
Gomber S, Dabas A, Bagmar S, Madhu SV. Glucose Homeostasis and Effect of Chelation on β Cell Function in Children With β-Thalassemia Major.J Pediatr Hematol Oncol 2018; 40(1):56-59. DOI: 10.1097/MPH.0000000000001043
Asadov C, Alimirzoeva Z, Mammadova T, Aliyeva G, Gafarova S, Mammadov J. β-Thalassemia intermedia: a comprehensive overview and novel approaches. Int J Hematol 2018; 108(1):5-21. DOI: 10.1007/s12185-018-2411-9.
ElAlfy MS, Khalil Elsherif NH, Ebeid FSE, Ismail EAR, Ahmed KA, Darwish YW, et al. Renal iron deposition by magnetic resonance imaging in pediatric β-thalassemia major patients: Rela- tion to renal biomarkers, total body iron and chelation therapy.Eur J Radiol 2018; 103:65-70. DOI: 10.1016/j.ejrad.2018.04.007.
Alkholy UM, Mohamed SA, Elhady M, Attar SE, Abdalmonem N, Zaki A. Vascular endothelial growth factor and pulmonary hypertension in children with beta thalassemia major.J Pediatr (Rio J) 2018. S0021-7557(18)30165-7.DOI: 10.1016/j.jped.2018.05.003.
Kalis Y, Malyutin Z, Shai E, Jahshan N, Dana M, Avraham L, JahshanN, et al. A mouse model to study thrombotic complications of thalassemia. Thromb Res 2015; 135(3):521-5. DOI: 10.1016/j.throm- res.2014.12.023.
Soltanpour MS, Davari K. The Correlation of Cardiac and Hepatic Hemosiderosis as Measured by T2*MRI Technique with Ferritin Levels and Hemochromatosis Gene Mutations in Iranian Patients with Beta Thalassemia Major.Oman Med J 2018; 33(1):48-54. DOI: 10.5001/omj.2018.09.
Vassalle C, Meloni A, Pistoia L, Gamberini MR, Spasiano A, Gerardi C,et al. Relationship between uric acid levels and cardiometabolic findings in a large cohort of β-thalassemia major patients. Biomark Med 2018; 12(4):341-348. DOI: 10.2217/ bmm-2017-0300.
Mancuso L, Vitrano A, Mancuso A, Sacco M, Ledda A, Maggio A. Left Ventricular Diastolic Dysfunction in β-Thalassemia Major with Heart Failure. Hemoglobin 2018; 42(1):68-71. DOI:10.1080/03630 269.2018.1451341.
Borgna-Pignatti C, Gamberini MR. Complications of thalassemia major and their treatment. Expert Rev Hematol 2011; 4(3):353-66. DOI: 10.1586/ ehm.11.29.
Notas de autor
Enlace alternativo
http://revistasum.umanizales.edu.co/ojs/index.php/archivosmedicina/article/view/2732 (html)